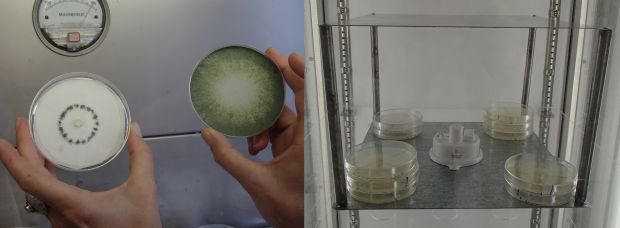
Trichoderma fungi growing on agar plates, and the experimental set-up that exposes all the plates to the same magnetic field

Our Changing World for Thursday 28 November 2013
Names and Faces

From left to right: Jamin Halberstadt, David Barton, Sam O’Sullivan and Helen Owen (image: Cindy Hall)
Does your name match your face? If it does, then people will like you more, according to research by PhD student David Barton at the University of Otago. Similarly, Masters student Sam O’Sullivan has found that the right names also just feel “right”. He’s been looking at a phenomenon discovered nearly a century ago called the Bouba/Kiki effect which matches spiky names to spiky shapes, and round names to round shapes. It seems that people like shapes more if they have the right “fitting” name. A concept called fluency.

From left to right: examples of a round and spiky shape, and a round and spiky face (images of faces: Gillian Rhodes)
Can the same be applied to people? It seems that it can, with spiky names suiting spiky faces, and round names suiting round faces. This was the follow-on research by David Barton, and he developed a way of quantifying the roundness and spikiness of faces based on chin angle. He then tried to determine which names are spiky and round, and got people to match them to faces. He found that people like faces better if they are given a name that “fits”.

A gender blend face with its male/female "parents" on left and right respectively (images: Gillian Rhodes, with morphing by Helen Owen and Annelyse Gelman)
Both students are supervised by Jamin Halberstadt and his research group also includes PhD student Helen Owen who is looking at faces and how they fit into categories. She has found that while people find feminine faces more attractive, if they have to categorise them into either male or female they like them less (or find them less attractive) in the ambiguous region of the male-female continuum.
Male and female faces
Helen Owen, from the University of Otago is looking at how well people's faces fit into male or female categories. See the related story Names and Faces.
Fungi And Geomagnetism
Agar plates with colonies of Trichoderma strain LU132 (left), and the experimental set-up that exposes all the agar plates to the same magnetic field (images: A. Ballance)
The beneficial fungus Trichoderma is a favourite with scientists at the Bio-protection Research Centre, but it has a slight quirk that got Lincoln University researcher Jo Steyaert wondering. For although the fungus has been kept in the dark at -80°C for the last 25 years, it still seems capable of detecting seasonal changes, despite not being exposed to the usual seasonal cues such as day length. Jo began to wonder if fungi could detect seasonal changes in the dailyvariation of the earth’s geomagnetic field, and she realised that Trichoderma is a perfect experimental subject as there are no confounding effects from other possible cues.
To find out how that led to a Marsden grant being undertaken with GNS Science magnetism expert Tony Hurst, Alison Ballance heads to Lincoln University, where Jo takes her into the lab to see some cultures of her favourite Trichoderma fungus, strain LU132. The research also involves researchers at the Slovak University of Technology who are carrying out identical experiments in the northern hemisphere.
Listen here for an earlier Our Changing World story about Trichoderma and the work of the Bio-protection Research Centre with Alison Stewart.
InterCoast
This week, we continue our exploration of collaborative efforts between scientists in New Zealand and Germany to mark the 60th anniversary of bilateral relations between the two countries. The InterCoast project is a joint venture between the University of Waikato and the University of Bremen, focusing on current trends in the environmental management of coastal regions.
The project was established in 2009 in a joint initiative between marine geologist Gerold Wefer, from the University of Bremen's Marum Institute, and the late Terry Healy, from Waikato University, whose friendship and collaboration go back to their days as post-doctoral scientists during the 1980s. The multi-disciplinary InterCoast team aims to cover all aspects of coastal and marine science as well as related international law and cultural issues. It deals with all challenges associated with coastal and shelf-sea areas subject to significant global changes. The first InterCoast students graduated last year, and over the next few years, nearly 40 international PhD students and post-doctoral fellows will study the Bay of Plenty coastline and aspects of the North Sea.
In this interview, Waikato University coastal ecologist Chris Battershill explains some of the projects that are currently underway, particularly following the Rena disaster.
Long-tailed Cuckoos on Hauturu-Little Barrier Island

Michael Anderson holding a long-tailed cuckoo (image: Mark Delaney)
Cuckoos are famous for laying their eggs in the nests of other birds – and not having a nest of their own makes them much harder to study than most birds. But transmitter technology has just advanced to the stage where it’s possible to tag them using tiny solar-powered transmitters that send location data back via satellite every second day.
Massey University post-doctoral researcher Michael Anderson is in the second year of a project looking at the movements of long-tailed cuckoos between their summer breeding grounds in New Zealand and winter feeding grounds in the Pacific, and for the story of One Flew Flew Over the Cuckoo Net Alison Ballance joins him on Hauturu-Little Barrier Island, in the Hauraki Gulf, where the team has to erect mist nets high in the forest canopy to catch the high-flying cuckoos.
The team was unsuccessful in catching any long-tailed cuckoos during their first 8-day trip, but Michael Anderson reports that has just returned from a second trip to the island and successfully managed to put transmitters on four birds. One bird has already made a 4-day visit from Hauturu-Little Barrier Island to Kawau Island, a round journey of about 60 kilometres.
Michael Anderson featured in an earlier Our Changing World story about Mohouidae, a new endemic bird family that encompasses the host birds of New Zealand cuckoos – long-tailed cuckoos lay their eggs in the nest of whiteheads, mohua and brown creepers, while shining cuckoos are brood parasites of grey warblers.

The cuckoo team erecting a mist net (left): the grey area in the middle of the photo is the fine black mist net, which appears invisible when suspended; Michael Anderson, Mark Delaney and Luis Ortiz Catedral next to a mist net that has been rolled up while not in use (images: A. Ballance)